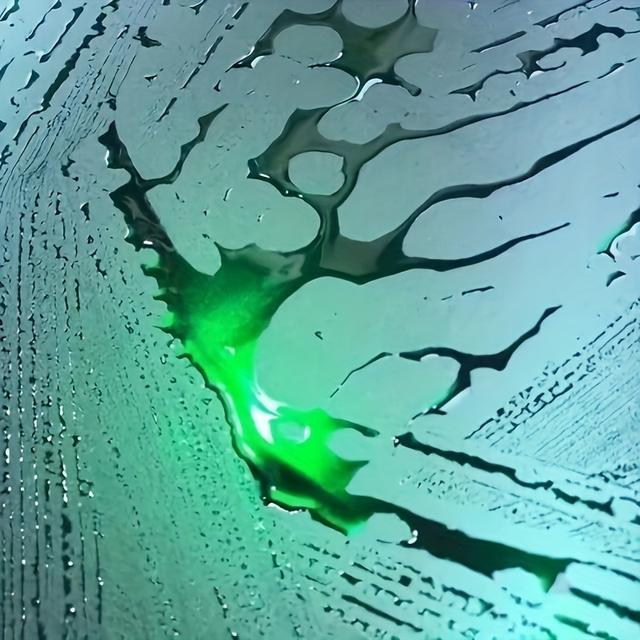
TEMU PET wasseraktivierbare, farbwechselnde, galvanisierte Giftgrün-Folie

Top Temu Deals & Price Drops for December 2025
Explore verified Temu discounts and price drops updated in the last 30 days.
All DealsDressesSpecialty ForksPillow InsertsBracelet PacksBarberFoil ShaversWaist CinchersShade ClothHandlebar BagsCradlesCardigansBlousesKeyrings & KeychainsGym TotesTopsOther (Socks)Track PantsPosters & PrintsSolar PanelsDuvet Cover SetsSteering CoversBaseball CapsTactical BackpacksBoxer BriefsCaddies & RacksSofa CoversGripsSun HatsFlat SheetsNail FormsYarnHair RollersSports DuffelsStudVarsity JacketsAccessoriesOuterwearPlannersSocksGift BagsSubject NotebooksT-ShirtsBallpoint PensNewsboy CapsBungee CordsTop-Handle BagsBasketballsPassport CoversAutomatic FeedersOverallsSeat Cover SetsBracelets SetsSetsNecklacesFashion ScarvesTool BoxesBlank Labeling TagsBed BlanketsStandsCase & Cover BundlesTools & UtensilsCasualPlus Size BlousesLayette SetsVisor AccessoriesTool BagsArea RugsDish RacksCamcorder CasesSpiral NotebooksDecalsPantsRompersRodsVestsTanks & CamisRingsCrossbody BagsCasesJewelry SetsCard StockSide-Cutting PliersOther (Accessories)Fashion SweatshirtsIndoor String LightsOver-the-Door HooksGarden StakesWalletsTeesCraft BellsPulloversBedsLaceDent Removal ToolsSpring SnapsCatchesWastebasketsLeathercraft KitsWireAthletic SocksWall CalendarsBelt BucklesBrushesKids' Bath TowelsTank TopsMedalsGrab HandlesBearing PullersPant SetsCutting MatsBox PacksCosmetic BagsRepair TapesPlus Size DressesAlarm ClocksDecorative BottlesSLR Camera LensesTopperHoopTap LightsMagnetic HooksStudent BackpacksLocknutsSubmersible PumpsPillowcasesFlip CasesGarlandsChannelsSweatsuitsBasic CasesSleep SetsBath Linen SetsMarkersWoven WigsBadge LanyardsOther (Tool Sets)BannersStickersStrapless TopsTripodsTraysKitsStockingsHoney JarsBike CoversSpring PinsScreen ProtectorsAdjustable WrenchesWall décorWall SculpturesDoormatsDispensing NozzlesTablecoversFloor Mats & MattingFashion HoodiesBells & Sleigh BellsToilet Paper HoldersPendant NecklacesStrobe LightsPolosSaucersPlus Size Tank TopsHatsPlus Size CardigansFleece JacketsTissue HoldersPaintbrush SetsDress ShirtsActive ShortsGift Wrap PaperPlace MatsName PlaquesClay MoldsPantiesRivetersTapestriesFigurinesNeedle-Nose PliersMilk FrothersRulersEquipment BagsBucket HatsManual JuicersLadies BlazerWall StickersHabitat DécorTravel DuffelsDry BagsCompression SocksCalf SocksCuffDrain AugersGarbage CansSqueegeesPunch MittsSeat PacksDome CamerasBumpersTool SetsDiversion SafesKnife Block SetsFaux FurGrillesJerseysPlus Size T-shirtsThrowsBusiness CardsWindshield SunshadesWall ChargersLace WigsWall PlannersDeep FryersCraft FoamMeat CleaversBedding12VPlaywearActive HoodiesBeach TowelsTattoo MachinesCoffee MugsPendant EnhancersBattery PacksHiking DaypacksSaddlesSelf-Stick NotesHeadbandsTable LampsOpen Storage BinsGarlic PressesLock BoxesArmchair SlipcoversSleeping BagsRare Earth MagnetsStatuesFiltersBath RugsWire CrimpersPlus Size T-ShirtsStockpotsShop ToolsBottlesHolstersStylusesActive SkortsActive SweatshirtsPlus Size CasualVinyl FlooringCandleholdersSmart LightExcavatorsMen's Chest BagSpray BottlesPump DispensersSteering WheelsBall OrnamentsPortable Power BanksWelding SystemsFlagpole HardwareGrow BagsMotion DetectorsFastenersPlanning BoardsFitted SheetsFairing KitsCoffee Cups & MugsComfortersRadiator FanArt SetsDesk & Shelf ClocksFloor MatsHanging OrganizersPantsuitsRash Guard ShirtsShort SetsBottomsHanging OrnamentsShoulder BagsTightsEarringsBookendsTrophiesNight LightsSeat FoamScissorsHighlight KitsGlitterApplique PatchesRoller BottlesHeat-Shrink TubingCosmetic CasesCollarsDessert SpoonsInsolesFuel FiltersBeaded BraceletsBridesmaid DressesCasual JacketsInsulationCapacitorsOther (Wrenches)Scissor Lift JacksResin Casting MoldsBeltsPlastic PlantsPlus Size ShortsPacking OrganizersHeadlampsFashion BackpacksLicense Plate FramesBriefsSkirtsSweatpantsBath Rug SetsBalance BoardsTable RunnersWall PedimentsFinger CotsPlus Size Women TopsShelf BasketsSaddle BagsJewelry BoxesCuffs & WrapsLinkToiletry BagsMouse PadsChokersRivet NutsDrop & DangleDisposable NapkinsTarpsKeychainsWeather StrippingFood StrainersClawsWomen's BackpacksReusable StrawsTackers & StaplersWater BottlesWall Molding & TrimCowboy HatsDrill AdaptersPantriesVideo ProjectorsGrowing LampsMattressesReplacement PartsCoolersBarsBed PillowsBattery ChargersTablesConcert CymbalsTable & Chair SetsPower InvertersBee HousesBarstoolsStandard HangersLED BulbsSunglassesShopping CartsSpa Storage SystemsSleep TopsOn-Ear HeadphonesDining SetsBookshelf AlbumsUmbrellasLitterCleaning KitsRotary ShaversHair ClippersFace MoisturizersLocks & LatchesStandard BallsShower Body SpraysPumpsTravel TotesLatchesBalance BikesChargersLaminating SuppliesBows & RibbonsFlatsClipsMounted PointsPonytailQuiltsActive DressesPresser FeetBladesLoose GemstonesArmrest CoversCarburetorsClothing SetsPaintingsPanelsThrow Pillow CoversEngagement RingsWallpaperEaselsTreesDecorative FencesHandheld FlashlightsSpotlightsFigure KitsHot Tub AccessoriesTorchesHardware ClothFoot BathsLint ScreensSteno PadsBoring Drill BitsRoom DividersPin BacksStanding Shelf UnitsLacing NeedlesDouble RodsGift BoxesThreadAlgae ScrapersSkullies & BeaniesComforter SetsInkjet Printer InkCandleholder SetsLeggingsSewing MachinesEnd TablesDining TablesShoe SlotsBluetooth HeadsetsGarment SteamersDining Room SetsMops & Bucket SetsDinnerware SetsFleeceCarbon Copy PaperScreensShooting TentsRakesFloating ShelvesSweatersBadge HoldersCookie StampsSoldering StationsEnclosuresVinyl WrapsFender FlaresPlayersCups & MugsInflation DevicesCylinder HeadsEau de ToiletteWrist WatchesZipline KitsESD Tool SetsTool HoldersChairsUtility KnivesDrawstring BagsCostumesLeaf BlowersShoe CabinetsTrampolinesWomen JeansFelt KitsCleaning ClothsFuel Leak DetectorsDuct TapeStatementRemote ControlsRacksPath LightsTowel SetsCoversSleepshirtsFountain PensAdvent CalendarsPants HangersPotsAbayas3D Wall PanelsGlovesAlbumsCurry CombsPlus Size CoatsHoldbacksEarbud HeadphonesOther (Hats & Caps)Nail Art PensBeaniesBathroom ShelvesBoard GamesScreens & CurtainsPedalboardsPutty KnivesVanitiesCell PhonesSteam CleanersCoffee TablesCabinet SafesOne PiecesJarsSofas & CouchesSuitsLotion ApplicatorsSkid PlatesBirdcagesElectric SlicersImpact WrenchesMattress ProtectorsGogglesVideo DoorbellsCabinets & CasesDressersDesk ChairsWall LightsBucklesBalloonsHome Office DesksTiebacksCuticle ProtectorsMoldsCostume MakeupNeon Accent LightsTree SkirtsDomesChainsawsReciprocating SawsHosesCorner ShelvesBidetsBar TablesCookware SetsIroning BoardsAir HornsMirror MountsSupply OrganizersForstner Drill BitsJewelry PliersPlus Size PolosJet PumpsPajama SetsMen's Watch BandsJump StartersCoops & CagesChef's KnivesOutdoor ShowersBuffets & SideboardsTemporary TattoosFedorasPlattersStorage ChestsTune-Up KitsDoor & Stair GatesHand TrucksTentsHumidorsHitting MatsCarsUtility HooksSweater PantsRope LightsLaundry HampersDecorative BallsCable TiesWeather ShieldsFansRope BarriersLint RemoversWreathsElectric VehiclesFood WarmersReceipt PrintersSkilletsHeat GunsHammer DrillsBoning KnivesCapsDrip Irrigation KitsTriggersHand BlendersPlaques & Wall ArtAttachmentsTunnelsArts & Crafts TapeSanding SheetsBath SheetsBookcasesPaint SprayersStorage BenchesSignal BoostersRatchet WrenchesDessert PlatesChainsOther (Embossing)Bay LightingMolding & CastingOutdoorCenter Drill InsertsInterfacingScrewdriversShearsBallsGift Wrap BowsSpeedometersTote Bag PacksPost LightsNotepadsVacuum SealersSports Water BottlesHair BrushesShower Curtain SetsFuel AdditivesRV & Trailer CoversCar ChargersGift Wrap TagsBottle OpenersWall ClocksLens ProtectorsGravel CleanersHeadboardsFoil EngravingAnkletsY-NecklacesTape MeasuresStrandUSB CablesChair SlipcoversStaff PaperLens AttachmentsRacing WheelsKids' CamerasDog HousesTowel WarmersConversation SetsMicrofiberPower StripsOttomansWinchesCargo BarsBenchesUnder-Bed StorageInvitationsLadlesCologneWood StampsNightstandsValve CapsMezzotint PrintsStraightenersSpotting ScopesDVIBorescopesTowel BarsOn-Dash CamerasSpa Beds & TablesLabel MakersBookshelf SpeakersFresco PaintingsPlus Size SkirtsElectric FireplacesBangleCrawlersGate LocksTie Rod EndsPower ConvertersSerum BottlesKnife SharpenersDrive Socket SetsPensHandlebarsIn-Dash NavigationOther (Hooks)LabelsEyewear FramesCharging StationsBracketsTow HooksNail DrillsLidded Storage BinsBench ClampsFlameless CandlesFuse HoldersOil PaintingsSquare DriveLightingFood Storage BagsBaking CupsBug ZappersOther (Props)FendersPower CordsPot RacksUSB Flash DrivesFolding UmbrellasFoosball TablesLighters3-D PuzzlesMosaic TilesGrommet KitsDrawstring Bag PacksClotheslinesWiring HarnessesAquarium LightsSocket WrenchesExercise BikesDrying RacksSignsSerumsLunch BoxesGreenhousesIn-Ground LightsShocksBed FramesAir Purifier FiltersBakewareLoofahsElectric BlanketsTie RodsWood Drill Bit SetsRaised Toilet SeatsCasting ToolsPruning SawsBeading KitsSqueeze BottlesOther (Headphones)TabletsSpoolsCrepe PansPaper Towel HoldersBistro SetsSprinkler HeadsStep LaddersArmchairsTurning ToolsHandlebar RisersButtChimesIce MachinesHandheld ShowerheadsTie Downs & AnchorsPicture HangersArtificial TreesSlide RailsPressure WashersHVAC BlowersDesk LampsDeck HardwareMedicine CabinetsFingertip TowelsWeed Barrier FabricRaised BedsBread KnivesBatteriesFramesHats & CapsColletsBathroom SetsFloor LampsClip-OnsCanopiesSkid SteersUndershirtsPlastic DeckingTool TraysVehiclesKitchen Trash CansFloor JacksStorage CartsFile SortersFreestanding SlidesAccessory SetsTruck CranesHitting NetsCarportsCarving SetsMen's BackpacksToastersHand-Feeding ToolsSofas & ChairsDining ChairsHair Treatment OilsToothpasteCenterpiecesHubcapsPipe CuttersManual ToothbrushesScrew GunsUtility CartsFlagsCookwareDrilling HammersValet & Suit StandsThreshold RampsPortable ClosetsBar SetsPlus Size Co-ordsMouthwashHands Free LeashesLaundry BasketsDetail SandersPOS & Register RollsSlippersCompression ShortsStandard Game DiceCases & WalletsVisorsBelt SandersKids' TricyclesNursery PotsDecorative SwagsPlatesSportsChocolate PotsClamps & StrapsLight BoxesSpace Saver BagsFloor MattingMemorials & FuneraryToy GolfBackpacksFurniture LegsBack & Seat CushionsArtificial PumpkinsPuzzle AccessoriesVGA CablesArtificial FlowersPulloverTent TarpsEau FraicheBody ChainsCreepersHammock ChairsNail PolishKitchen RugsToner CartridgesStorage Drawer UnitsWashesPlugsRunnersMassage OilsKeyed PadlocksSiftersMassagerStickers & DecalsVacuum Sealer BagsVasesKnitwearHoodiesHeeled SandalsColandersFidget RingsHooksBeach ToysDigital ScalesLunch BagsBootsTransfer PaperSpatulasWire SetsAnti-Dust PlugsMonitor StandsStorage BoxesButtons & PinsOxfordsPleated ShadesOutdoor VolleyballsMobilesHeadlight BulbsWooden Lead PencilsOther (Decorations)TurnbucklesTractorsDrooling BibsGaming KeyboardsPaddleballShoe CoversHandheld MassagersDip Manicure KitsGirlsFog LightsArtificial FruitDesk Pads & BlottersCandy MoldsAir FreshenersPocket WatchesBath & Hooded TowelsJacketsTile CuttersUnfinished WoodPortable DryersWool & BlendsWomen Fashion GlovesApplicatorsBraided LineProtective SleevesTeacupsRolling PinsPlug ConnectorsGeneralBrushes & DustersCC CreamsSatchelsBean BagsBasketballCharmsWelding WireThumb GripsDumbbellsSoup SpoonsTest ProbesFork GuardsTableclothsCase & Storage SetsCamisoles & TanksEyebrow ColorCake StandsPull-Out OrganizersClayPedestalsLumberIncense HoldersPencil SharpenersTunicsHeadwearFountainsOther (Underwear)Lip GlossesCup & Saucer SetsJeansBath SpongesUSB Network AdaptersModeling CompoundsPlush ToysSlidesGrowing MediaHand TowelsElectric ToothbrushCable SleevesZippersResistance BandsHandwriting AidsMagnetic BuildingReboundersTanks TopsPajamasKey ShellsDisplay StandsCars & Race CarsSoft-Sided CarriersKeypads & RemotesOilsFolkcraftsPlus Size OverallsLipstickCutting BoardsUSB LampsChocolate MoldsRoundLanternsTotesComponent TestersPower Door LockShovelsConcealedSoap DishesSheersParchmentToenail ClippersStreamersMakeup MirrorsBeanies & Knit HatsStore SignsKnee BracesCupsDecorative TraysTable DolliesGrip StrengthenersSteering GearNeon SignsAll-Purpose LabelsKnee-HighOther (Shoes)Water ShoesBattery HoldersLoafers & Slip-OnsClaspPlastic CareFoot PumicesDuvet CoversSwitchesPaintsHome Gym SystemsSide MirrorsRemovable LabelsHelmetsCricketExterior MirrorsApronsHandlebar MountsSink DrainsAdhesive BandagesPosing PropsZestersElectrical TapeVoltage TestersCalligraphy PensPushbutton SwitchesBB CreamsShirtsNecktiesSunglasses & EyewearCrayonsDecorative PaperExercise MatsScoreboards & TimersSoapsSquare Cake PansGratersStorage Bins & BoxesSweatshirtsPaper TowelsMagnetic FramesDrying MittsToothbrush HoldersRefrigerator MagnetsShoe BagsFashion SneakersAnkle & BootieSecuring StrapsSoftshell JacketsSnow SuitsLabeling TapesBun & Crown ShapersCup HoldersCrate PadsFurnitureScooterPlaquesBraceletsAccessory Light KitsPeelersInflatable BouncersBottle Drying RacksStroller HooksTable PadsCake CarriersHeadphonesPencil DrawingsOrnament HooksBlanketsDownMary JanePersonal OrganizersTrunk OrganizersEnclosure CardsPlus Size SweatersNut CrackersStrikesArmrestsGarment CoversRugsFurniture SetsBack ScratchersTimersScars & WoundsAcoustic ViolinsShrink WrappersElectric LanternsBradsPuzzle BoxesConfettiPizza PeelsSafety PinsCorrugated PadsFinger SplintsEMF MetersWomen Bracelet SetClampsSpring ScalesBack BracesPaint BrushesBirthday CandlesBallet & DancePlus Size SuitsTape CaulkDessert BowlsEyelinerFrogs & KenzansCookie CuttersCoat CareReflective GearID TagsWindow StickersTrellisesAromatherapy CandlesJewelry ClaspsScales & BalancesWomen Rope BraceletFluorocarbon LineStaple RemoversFriction TapeTrenchcoatsFruit BowlsSeat CushionsString LightsBath TowelsHygiene & SanitationCylindersStorageEggsSleeping MasksPipe ClampsJoinery BitsServing TraysCountertop BlendersEmbroidered AppliquéParty PacksDoughDVI-HDMI AdaptersPencil CaseCeiling FansUltrasonic RepellersPlush FiguresBoy ShortsChew ToysSmart Light StripPermanent MarkersMounting TapeMasksHeavy BagsMassage SticksCamera CasesIce Pop MoldsGarden EdgingParing KnivesWristbandsCamping StovesEye PinsCosmetic InstrumentWaffle IronsAluminum FoilJewelryReusable UnderpadsDartboardsRod RacksAddress SignsPendantsPasta BowlsScrub JacketsTrains & TramsLight BarsDust MopsPhoto PaperDroppersAbacusesContainer SetsFreezer PaperStencils & TemplatesEvening BagsMemory Card CasesBoot & Shoe CoversStorage File BoxesLadder BallStage Speaker StandsPot Lid HoldersLap CountersLeather CareEveryday BrasSprinklersDrill Bit ExtensionsRoad RunningRain ShoesPlus Size SetsHealing CrystalsKayak AccessoriesBikinisTasselsTipsFaucet Mount FiltersExercise BallsHeadlightsCombination WrenchesViewfindersPlus Size TightsScalp MassagersCandlestick HoldersTowel RacksHeel Cushions & CupsIronsPillow CoversValve PartsHDMI CablesBrake CleanersTire GaugesShoe HornsNestsVideo ConvertersLitter Box LinersCompressionAdhesivesSmartwatchDonut PansBattery TestersCoffee ContainersJars & Jar HoldersCard SleevesCue Tip ToolsGreeting CardsStaplers & TackersEntry GuardsTeapotsCleaning & CareFootiesDiffusersLingerie SetsSand ArtLabel HoldersMandolinesOmelet PansInsect repellentBeretsRing TossRepair KitsJewelry Making KitsCreamsUtensil HooksPearl StrandsRobe & Towel HooksLip LinersFalse LashesSpongesSkirt SetsMittensPencil HoldersLens CasesPullsDigital CalipersClutchesWatercolor PaperGlasses & GogglesOrthodontic SuppliesShellsAir Pump AccessoriesControlsDollsGlass Cutting ToolsLace AppliquéRepair Tools & KitsPendant LightsBike MirrorsSeat Back OrganizersBuilding Sets搬家袋Other (Toy Sports)Lip StainsSmartwatch BandsClothingCasual DaypacksDrill ChucksDoor Entry GuardBath PillowsAcrylic LiquidsKey Ring FindingsRepeatersGel PolishBody PaintTabletop SignsBread BasketsTrunksPencilsMen'sShortsIdentificationSandalsRound PaintbrushesJewelry RollsBirth AnnouncementsWatch SetsKeyboard CasesMakeup OrganizersLiners & Ankle SocksCoat HooksBeard ConditionersFeeding MatsTool KitsHair CombsBread BoxesPhone CharmsHanging Hook StandsSets & KitsSteamersMakeup SetsSuncatchersStencilsContainersSnatch BlocksStackingSharpening StonesMiniaturesProtective SkinsBar Sink FaucetsSleep Bottoms开放式耳机Bra ExtendersWomen Bag SetsDinner PlatesElastics & TiesPhotobooth PropsCoaxial SpeakersFuse BoxesJewelry TraysBase CoatFurniture CupsFingernail ClippersPot WashersScratching PadsBoxersForksBroochesPants & CaprisDecorative BookendsLamp ShadesPowder PuffsBaking MatsCrochet HooksSewingFixed ShowerheadsEdge & Corner GuardsFashion HeadbandsWraps & PashminasHouse NumbersTrench CoatsFloral FoamCloth NapkinsReed Diffuser OilsCreams & LotionsBackgroundsSweater Co-ordsConditionersAIR PipesPlanning PadsClothes PinsReceiving BlanketsWaist PacksGelReferenceWheel CareRobesStereo MicroscopesTissue Pom PomsFoam RollersReed Diffuser SetsGarment RacksBathtub MatsLuggage SetsStairs & StepsShampoosShower MirrorsSeat CoversCotsSafety Work GlovesGrip Repair KitsGift Wrap RibbonsCuff RingsBurp ClothsDispensing NeedlesKnobsDenimTicketsJigsaw PuzzlesShoelacesPlay ToolsCake Pop MoldsMedical KitsToysCut-Off WheelsNail StrengtheningLight AttractantsCupcake StandsRice ContainersWedgesNumeric KeypadsSpring ClampsToy BasketballTattoo Machine PartsStereo Jack CablesSealsHeat PatchesButtonsHandheld VacuumsCash & Check BoxesAircraftGrout CleanerStep Drill BitsChukkaWaxPajama BottomsReelsTree ToppersBrush CleanersAdjustable HandlesHingesCam-Type ConnectorsSealing WashersBlushCasserolesRoadway SystemsTinted Lip BalmBumper StickersHidden CamerasCatnip ToysEyesMeat GrindersDoor StopsVanity LightsChopsticksEgg CupsCastersBagsSpecial OccasionHandbag HangersBasic BowlsStem CastersLearning SystemsWireless ChargersJumpsuitsFace CoveringVents & Deck PlatesSpoon RestsUSB MicroscopesCraft ShearsDesoldering WicksTiersSwing TrainersEyeshadowEyebrow ScissorsEmblemsEye PatchesSkateboardingTravel GamesPowderDental FlossBoot & Shoe BoxesHeadwrapsPipe CleanersEyeboltsCooling PadsGame PiecesUSB HubsDental DamsTurn Signal BulbsCube ErasersLaundry BagsBrake Flaring ToolsPurse MakingMonocularsPlastic Bag HoldersMascaraDried FlowersComplete TripodsCold Weather GlovesSalad BowlsReplacement CleatsRibbonsReplacement HeadsMesh & Wire ClothFaucet Spray HosesClipboardsAnoraksCellulite MassagersSnake GrabbersMirrorsLeak Detection ToolsHair DryersIroning AccessoriesFlexible MagnetsRash Guard SetsNeck GaitersMasking TapeDoorstopsBarrettesPostcardsScrew-In HooksFire RingsExternal FlashesControllersPlatformsBeard OilsSofasMatcha BowlsIndustrial TweezersThreadersBathroom TraysShelvesExpansion PlugsHandheld MirrorsPress On NailsFusesSlipper SocksFood Bags Chip ClipsHat BoxesPea CoatsYarn StorageSleevesSelfie LightsBluetooth Car KitsActivewearTrailersTie-DownsNail Art BrushesFlat WashersArt KnivesSpacersDropping PipettesDrain StrainersSelf-Feed Drill BitsTemplatesDimmer SwitchesPatternsDish Scouring PadsMice & Animal ToysNapkin RingsSkins & DecalsAdhesive CaulkWindow Tinting KitsMoisturizing SocksMen Bag SetsBaby DiapersBridal VeilsPaint EdgersBoot KitsPegged PuzzlesMittsHairdressing CapesTree StorageDrawer OrganizersTire Valve ToolsTool BeltsFloor GamesBody GroomersKnee-High SocksToilet TissueFaux CollarSquare NutsWindow FilmsFabricMountsFuton SetsShrugsCharmRug Grip Tape & PadsCold Weather ScarvesMixing BowlsBronzersFlatware SetsBasicBubble MakersArmsSand & Water TablesWashclothsBed MatsTravel PillowsPadsBoxesDraw & TensionSmart LockMixed MediaHanging OrnamentCircular SawsBall-Peen HammersToilet PaperScrewdriver SetsPen-Style ErasersSmartwatch CasesBox MailersPipesPlus Size Calf SocksCake RingsTable FansQuilt SetsVoltmeterDie-CutsPipe WrenchesAccessory KitsPotholdersSteering AccessoriesSofa PartsEyeletsPlus Size JeansHoof CareSinglesGoalsLeathercraft RivetsDoorsPlus Size VestsBack MassagersUtility RacksCoastersTrucksRack AccessoriesSequin TrimRod HoldersMattress EncasementsBarbecue TongsFireplace ScreensS-HooksBreast PetalsPlush PillowsFigurine LampsDive Rings & ToysUSB FansBalmsEyeglass CasesShower CaddiesHydration PacksSkimmersHeat Transfer FilmCoat RacksAngle GrindersFoam Sleeping MatsTravel CasesBooster & Car SeatsPin PunchesLine LasersPill OrganizersOil Lube SystemsCoats & JacketsDryer BallsEyelash AdhesivesIDC ElectricalBasic CollarsMen's Waist PacksBalaclavasScrapbooking StorageTrail & Game CamerasUtility ShelvesChair DolliesDisplay CasesHand GripsSoft LuresCentrifugal JuicersBox TissuesCat Houses & CondosPick HoldersDriving GlovesSanding SpongesTrimTongue CleanersGift & Apparel BoxesTraining BrasEmbroidery & CrewelUnder-Cabinet LightsWire CuttersBathtub TraysToy SoccerAppetizer PlatesPlus Size Knit TopsAlto SaxSausage StuffersElectric RazorEarmuffsKnee GuardsEmbossersControl CablesCurtainsHeat Transfer PaperComplete MotorsHollow-Wall AnchorsRepair PatchesPot Filler FaucetsHip & Waist SupportsFacial RollersVocalNetsCarry-OnsFolding ChairsCable RacewaysOther (Photo Studio)Snow BootsGoalkeeper GlovesShelf LinersCyclingMen's Safety ShoesVanity SidesplashesPotpourrisArtificial TopiariesCart BagsStrut CompressorsWearable BlanketsTabletop FountainsCeramic MagnetsNail TipsSnow GlobesSweater DressHammocksDrawing PaperShower Curtain RingsTreadsCake & Pizza CirclesPlus Size PantiesRopesFitness EquipmentSecurity Lock BoxesDrawingIcing & Piping TipsWrapDyesHeadlight BracketsPillowsSummer Sleeping MatHome Office CabinetsDress SuitsMantel ClocksSprayersHeat ShieldsMonopodsString TrimmersHand RestsPins & TacksFoundation PrimersScrub SetsBidet FaucetsHandling SuppliesMacrame & KnottingOil Pressure ToolsSkirt SuitsCase FansCarpet & VinylToolsCanvas ShoeTea KettlesTwo-Way RadiosBlazersBento BoxesScrub TopsCoat HangersTuxedo ShirtsCover-UpsPaint RollersSuitcasesHighlightersCondiment PotsTire & Wheel SetsStorage RacksDispensing BottlesShapesuit SetsHipstersSling ChairsPolishing & BuffingButton-Down ShirtsParking GadgetsLift SupportsPlayground BallsEngravingsSound EffectsFender ProtectorsSpice RacksStampsTurning InsertsNapkinsAnkle SupportsStand MixersCandy BottlesSpecimensWigsDecorative BellsConverter PartsHat RacksKnee PadsSaucepansParts & ConnectorsWet FliesPlaypensHiking BootsStopsFraming NailsPlant CoversIndoor Bike StorageNail Studio SetsDecksPinstriping TapeTromboneCar Rack AccessoriesFloor Cord CoversVernier CalipersOne-PiecesPalettesKnits & TeesCrochet KitsStick UmbrellasMoth ProtectionAir FryersJigsPaperTwo Piece TopsOrnamentsKey HooksAirplane & Jet KitsPrinter StandsDehumidifiersPegboard HooksWheelsCard CasesThrottlesPoker Table TopsBath & Body BrushesLampshadesScratching PostsHanging PlantersRampsHealth SuppliesPoultry FeedersIron-on TransfersTrachten JacketsMicrodermabrasionFunnelsHole Saw Pilot BitsShacklesSuit SetsWet-Dry VacuumsGarden NettingMen's Canvas ShoesTool CabinetsTactical VestsFurniture Set CoversLoading RampsCue SticksSensory Motor AidsTrachten CardigansSelf-Watering StakesUmbrella RacksCooking SpoonsHalf SlipsStakesLensesLinguisticsAutomobile ChargersBoxing PadsDriving LightsDeburring CuttersOil Drain PlugsCondiment RacksTennisDécorMakeup AirbrushesEpilatorsHair Cutting KitsShoulder SupportsWatch WindersTransfer PunchesDice GamesDivot ToolsBodysuitsEnd PipesPod DrawersOther (Leathercraft)Memory Card ReadersTrays & BagsCake TestersStem CapsHanging BasketsDisposable UnderpadsShower CurtainsMaternity PillowsFigurine LightsElectric HoistsTraining ClickersTop CoversSpeaker MountsBlind Spot MirrorsCenter PunchesBias TapeAudio AdaptersPlay FoodToy FootballDashikisCandlesticksOutdoor StatuesFolding FansBlenders & SpongesHardwareRod Cases & TubesStand BagsLinear Motion GuidesPractice Nail TipsMelodicasCard AlbumsHair BunsLeveling CompoundsOpen-End WrenchesGrill PansKnitting KitsScratch BrushesLED Strip LightsJig AccessoriesWomen Denim SkirtsSunroofsBulletin BoardsThigh SlimmersFeedersRole Playing DiceCore Drill BitsHex-Shank Drill BitsLightning CablesHandkerchiefsSheet Music StandsGazebosEmbellishmentsBinding CoversWallpaper BordersRoof VentsBark CollarsPicnic BasketsTie SetsWomen Denim TopsShoe BrushesFlooring & CarpetingFlexible LinersClaw CareFictionJackets & CoatsPull-Up BarsCurtain TracksAgricultural FencingLederhosenReusable BagsBed Rail CoversWall-Mount MailboxesGame & Trail CamerasStudsMotorcycle LiftsSandMultipurposeFloor Molding & TrimSalamiTables & TabletopsNutcrackersTrain CasesAngle ClampsShedding ToolsAuger Drill BitsLotion DispensersWindscreensBreakfast TraysBeakersRotary ToolsSeaming TapeSchool ChairsRain BootsFoot PegsArtificial SnowBuffing WheelsWindow PerchesMP3 & MP4 PlayersHandheld CB RadiosOther (Printmaking)Walk-In BathtubsBrayersSlow FeedersContact CementsManual Lawn AeratorsDoorBasket StrainersPiñatasHitch PinsChair CoversCanister VacuumsPepper MillsStepsCable & Wire RopeHarmonicasDecorating KitsRaised BowlsEscutcheonsCanteensWorkstandsCordsCandy ServersFan BrushesBinocularsTopwater LuresMug HooksPlate CastersScreen RoomsStopwatchesSquaresScissors & ShearsSugar Packet HoldersFabric RibbonsRocksKaftanInstaller BitsOrigami PaperStacking BlocksTambourinesSnap Grip ClampsDecorative BoxesActive SetsAdult HelmetsOutdoor CurtainsCleaning BrushesPedal Boards & CasesJewelry TowersFoot SpasTripod HeadsOther (Golf)Dome LightsRecycling BinsLuggage RacksGarden CartsDashboard OrnamentPaint ScrapersCarriersFly Tying MaterialsCheese PlatesPaints & FinishesFoot MassagersShower & Wall MountsDeodorantTabletop ScenesHanging ShelvesC-ClampsEgg TraysFeeding BibsTuningDecks & SetsJar CandlesGame TablesReplacement FuelHeadlight BezelsSublimation PaperRain PonchosEarpadsMules & ClogsExercise WheelsCall BellsProtective ShieldsPainting Tool KitsFrench Memo BoardsMatcha SetsNail Drill BitsShoe TreesItalian StyleTailgateWindshield De-IcersGlove Box OrganizersGarage Wall GuardsCheese SlicersTargetsUtensil RacksBluetooth SpeakersBustsDownspoutsWine GlassesCargo LinersCoatingsFiling EnvelopesPunchingCollar CharmsWall-Mounted MirrorsPuller SetsTailgate NetsSoft BoxesGermination KitsShower Curtain RodsColor-Coding LabelsTang JacketsShock BushingsMascara BrushesIndex Card StorageFaux LeatherBasic LeashesFull Car CoversGas CapsBooms & StandsInsulatedCold Weather CoatsAcrylic Nail ToolsHoldersKeyring PacksStretchVacuumsPry BarsTurntablesBattery ConvertersScribersSuspendersClip Photo HoldersSuit JacketsStabilizersRange BallsPostal ScalesBall MarkersTent StakesPlus Size FleeceUSB-to-USB AdaptersBumper GuardsTable Tennis SetsSanding RollsJackets by ActivityLeadersFoot RestsDartsKurta SetsGaffer TapeBoot TreesShiftBookmarksPlus Size LeggingsBarriersTravel Carry BagsMultimetersStarter SetsFurniture SlidersTransparent TapeJingle BellsHose TimersSports RacksFly LineGear KitCard BoxesNail DryersExhaust FansStage LightsWet/Dry VacuumsBarrel Fuel PumpsOutlet CoversAspirator PumpsViolinEnlarger AccessoriesDesktop StaplersTiming Belt ToolsHenleysMortar & PestlesPivotPaint Brush HoldersWatering CansSpring Tension RodsIntake ManifoldsShower PanelsClosureOnesiesLocking DevicesAgility LaddersCellophane WrapDog Treat PouchesDocking StationsOutdoor RugsPlus Size KimonosShapesBags & CasesFloral Tapes & WrapsTool ApronsCushionsClimbingBaby Gyms & PlaymatsJob Site LightingPop FiltersSpeed ChutesHand Fuel PumpsGuardsCasual setsPepper ShakersHandguardsFuton SlipcoversFuel LinesPizza Delivery BagsOther (Men)Clip RingsSwiss Pattern FilesMCU ControlAnniversary RingsFlasksFishing GlovesKneeling CushionsCandelabrasBook CoversWorkbenchesGrommetsStrapsDry Erase BoardsTraining PuttersClear StampsCrimpersConnectorsFringe TrimAir MattressesBall RetrieversCookware AccessoriesDeck BoxesStoolsPen RefillsTower FansBatteries & ChargersHeadersEarwax RemovalTurning HoldersCargo TrailersBody SpraysEdgersActive TracksuitsRadiatorBench VisesKids' BackpacksGuestbooksStep PlatformsDown AlternativeDrill & Tap SetsCircuit OpeningFilter AccessoriesFelt WheelsDVD CasesWindshield SqueegeesVehicle CoversBed PadsTrim KitsAlarm SystemsTea ScoopsWatch BandsHandbag OrganizersTree StandsSubland Drill BitsArtificial GrassBundlesTool ChestsMetal Stamping ToolsPack PocketsTea Ball StrainersHole SawsPutting MatsAdjustable BenchesIncenseCrib BumpersLap DesksJewelry ChestsCoffee ScoopsFootprintsTube SqueezersElectric BicyclesClearfloor LiftsLip ButtersTactical FlashlightsBowl SetsAntennasCalipersPractice NetsAV Carts & StandsPortableRack ShelvesHot-Air BrushesRowersLounge ChairsExtractorsGrease GunsPower Water PumpsCooling BinsStartersRail PlantersJewelry ArmoiresCue RacksRobotic VacuumsWater CoolersChoppersSmart Trash CanDeck LightsToe RingsSnap-Ring PliersUpper Body MachinesDrill DriversSeating AccessoriesPlanner AccessoriesInterior LightingStage Laser LightsCartsBlower FansChain BarriersStools & Bar ChairsGrow TentsMechanical PencilsBuilt-in TimersPorch SwingsMattress ToppersBottle JacksShowersStorage ShedsInversion EquipmentIndoor ThermometersBullet CamerasWater FiltersNovelty CoinsImpact DriversKeyswitchesWiper KitsExhaust Pipes & TipsCharcoal GrillsPlus Size Cover UpsSuction HosesOther (Grooming)KettlebellsWood FillerSpark PlugsBlade StorageSD CardsCable StrapsHair TowelsRash GuardsMicro SD CardsGarden HosesSalon & Spa StoolsPolishers & BuffersWaste BinsBandsEternity RingsGlidersSnapsVessel SinksDVD-VCR CombosHook & Loop DiscsStorage ClipboardsWindbreakersRemote TriggersBrooches & PinsScarf OrganizersTassel CharmsMuralsWind SpinnersWood Burning ToolsTap & Die SetsSwing Arm SpoolsWater HeatersFlood & PerimeterFly SwattersLiquid White GluesRoutersCooling RacksClocks & BarometersLinensFoilDisplay TablesDeck PartsConduit FittingsPersonal FansDishesCircuit BreakerRubber BandsAir DamsOttoman CoversSeatsReplacement SensorsCoffee MachinesCarpet Chair MatsEnd Mill HoldersHole Saw SetsPhotographsMotorcycleHealth Care DeliverySneakersATVsMid-CalfSwim CapsElastic BandsFlying DiscsTray CartsAir Suspension KitsFender SkirtsWalkingBody Mounted CamerasVest HarnessesPizza PansGrill BrushesMoussesOther (Words)Boat SeatsPlush PuppetsCutting BurrsSpoilersEspresso CupsTechnical PensDecorative PlatesSofa Throw CoversBike Racks & StandsTelescopesTrailer StepsMarble TilesScalesOther (Ornaments)Plus Size PantsKey CabinetsSpaceshipsFishing KitsInfusion MugsRacquet GripsSwaddling BlanketsRoot Lifting PowdersDoor GuardsStampingColoredComforter ClipsOther (Bracelets)Other (Painting)Smart Aroma DiffuserTea Light HoldersFitness TrampolinesAlarm AccessoriesMountaineering BootsWall SafesServing SetsKitchen PlaysetsHijabsBulldozersWomen'sTent CardsDiapersCuttersPanty LinersWater SpittersPermanent FiltersCombs & SpinesLabel PrintersShooter SleevesPunchesWalkie TalkiesModeling Toolswig toolsFoot FilesLED Accent LightsBench ScalesAdhesive WaxingUnitardsTaillightsOther (Toys)Inkjet Printer PaperBath Towel BarsBriefcasesBall Pit BallsNail Files & BuffersTrivetsGelsShower DispensersJumpsuits & RompersMilitary & TacticalBarbecue SkewersMiceHeating ElementsTeapot WarmersBeverage WarmersSafety RazorsShopping BasketsLuggage ScalesTampersPod BasketsAroma DiffusersBoysStacking GamesProximity CardsTouch On FaucetsNeon Light TubesPlay & Swing SetsTowelsMixed Drinkware SetsTorque WrenchesSmart BulbDrying HoodsCloth Face MasksGrill FansGift SetsSpeaker CablesFoot WarmersCenter ConsolesEyewearWater PumpsBolt SnapsFidget SpinnersAction FiguresEmergency BlanketsBunting BagsPower ScrewdriversPlastic WrapSmart JewelryHole PunchesBuffing KitsToilet Lid DecalsSherwanisDraft StoppersDried PlantsVase FillersPond FountainsCombsPittersPill DispensersBody GlitterIndex TabsMotor VehiclesBrow BrushesToggleDrum SetsLight SocketsManualEgg PoachersCombo KitsBiometricsCuticle OilsPlus Size SweatsuitsEngineeringPlus Size Flat FrontOven MittsGlue Gun SticksFlash CardsAcrylic PaintingsTools & AccessoriesTape DecksReplacement KitsRisersTrain SetsRacquet CoversCoffeemaker PotsDeadboltsDressSelf-Tapping ScrewsTinselFlatware OrganizersElectrode HoldersMagnifiersAeratorsPerchesDrain PlugCaulking GunsTea FiltersWaxesMatsOutside Micrometerslip oilStorage TrunksFoundationRain JacketsTemperature SensorsEgg CookersSugar BowlsMoney BanksEvaporative CoolersWarmersBunion SplintsTubing & HosesSushi PlatesRainwearFender TrimBib HoldersWomen Denim ShortsSanitary NapkinsPotato MashersPocket SquaresHand BroomsWall Lamps & SconcesLamps & LightingMemo HoldersRotary LasersHot Water BottlesStaplesLevelsDrawing BoardsBrush Sets3D Printing FilamentMarking ToolsWheel AdaptersWomen Denim DressLaptop StandsFinger PuppetsReflectorsRefrigeratorsDry ShampoosThicknessCollectible VehiclesHot PotsFootbagsCat 6 CablesSnowDrains & StrainersElbow WrapsRamekinsIce CrushersOver-Ear HeadphonesPool BrushesWood ChiselsHandlebar TapeLevelersRecipe HoldersProfessionalPrintmaking InksKeyboardsDresses & RobesBicep SupportsCD & DVD DrivesShower CapsTraining PantsTire Repair ToolsUniversal FittingsLitter MatsBorders & TrimmersLeg WarmersDecorative JarsWrapping TissueReusable Pad LinersAquarium Test KitsElectrical WireWrapping SetsPlantersTattoo KitsHair MasksCamping PillowsAdaptersReplacement BandsMedicine DispensersGartersBowling PinsAquariumsYogaUpright FiltersOverhead VideoTile GamesReading GlassesCombination PadlocksServewareIce Cream ScoopsLive PlantsTwist TiesReplacement WheelsInteractive ToysExtension CordsChef PantsSheetsBall StorageVeneersOther (Snaps)SharpenersAisle RunnersPaintbrushesDisco Ball LampsSnack BowlsStyling TreatmentsMarble RunsCleanersChain & Rope SnapsItem FindersWood PolishDashboardsFoam WedgesBelt DisplaysWrite-On SignsCuff LinksPackaging PeanutsFusible TapeChest ExpandersRaincoatsJobber Drill BitsCaddiesHair TonicsCoffee ServersBinder PocketsFeather DustersNursing PadsFootrestsStamped KitsGermination TraysPainter's TapeNasal StripsWet MopsCandlesPushup StandsWig Head StandsBingo BallsTerrarium BowlsBath SeatsEnvelope MailersFood ProcessorsMelon BallersHelmet AccessoriesOther (Woodcrafts)Safety GogglesBiscuits & PlugsWeight BeltsProtractorsBandanasHead CoversMen's Key CasesDental Water JetRocking ChairsArtist Trading CardsChangersSnow BrushesTailors AwlBlade PuttersFootball MachinesBow TiesStemsBelt RacksSinging BowlsTraining EquipmentGrill BurnersGlove LinersOther (Body Jewelry)Slip-Joint PliersWig CapsLuggage StrapsWomen's Chest BagPlanner RefillsDry BoxesTrekking PolesDoor ArmorGate HandlesDrawer SlidesGaugesBooksWomen's Waist PacksWedding RingsBait StorageSATA CablesLeadsWater Bottle CagesChair PadsU-LocksRelish DishesBoat FendersDecorative StonesHeadsComputer SpeakersTeasersCue TipsPrinter TraysCorbelsBilliard BallsDryer AttachmentsFender GuardsBedding & LitterStudents ScissorsCroquetParts & AccessoriesWheelbarrowsStorage CabinetsBed CoversAthletic BottomsSideTankinisVacuum HosesFly Rod Cases & BagsPiercing KitsFeather ToysParacordBallBeaded AppliquéShear & Razor CasesAftermarket SystemsPeanutsPull HandlesBasketball StorageBattery SwitchesPortable BathtubsMisting SystemsFolding Shoe RacksMug SetsCredenzasOther (Pork)Disposable WipesBeatersFolding TablesMinisWindows & SkylightsCarpet SteamersSake SetsInsect HotelsMessenger BagsLaser PrintersGrinders & PolishersSonicRoller StandsHousingsWaversDown JacketsSoup LadlesTable BasesSingle BowlRice CookersStandard SkateboardsBait TrapsCrochet PatternspH MetersPedalsTire SpoonsBrake Line ToolsSaxophonesSeat LinersPlate Storage RacksSafety MirrorsOther (Snack Foods)Cooler AccessoriesBridal HeadwearFishing KayaksTable CoversOil Filter WrenchesStandard FlightsOther (Pliers)Ball CastersGriddlesRaised Garden KitsPaper LanternsBustiersPartitionsGhillie ShirtsStep LightsChaise Lounge CoversSensor BlocksBeneficial InsectsWater Test KitsDie GrindersTurbochargerGlasswareBook LightsBags, Cases & CoversRear Facing MirrorsLumbar SupportsFloor Stand SignsDumbbell RacksWicksSewing StorageCupcake CarriersDesk CalendarsPower SuppliesGarment BagsWire Rope ClampsPaint SpongesHedge TrimmersTortilla ServersKids' LuggageCardiganAndironsPegboardPrivacy SheltersScarvesPlus Size SheersBasket LinersUpright VacuumsDigitalTire ChangersPennants & BannersOdor RemoversScalp TreatmentsBath BombsCagesFire StartersFoam FlooringCafé Curtain RingsGrill CoversJackets by SportMenu HoldersSingle RodsAdhesive VinylPoster FramesDiving MasksEssaysCanistersCrane ScalesTow StrapsMultipleSports BrasLapdesksMusical ToysStamp AlbumsThermal ImagersCallus TrimmersTiresModel AnimalsCajonsTrailer DolliesDental Care KitsCorersTrays & RacksKnitting NeedlesCold PacksWeapons & ArmorSmartwatch CablesHeadlight EyebrowsLatches & BoltsHair Building FibersSocket Head ScrewsDoor & Window BitsBathsAcupunctureSmart DoorbellSocks & InsolesHand-Screw ClampsHair SpraysPower Door Lock KitTop CoatThreading DiesWoodTraining LeashesMotorcyclesWater StorageHand WarmersSplatter ScreensHose Clamping ToolsShooting TablesHeatersMincersTactical Fanny PacksTattoo NeedlesReplacement BladesClutchPebblesSqueak ToysTable SkirtsSlide HammersSnow SledsSeam RippersFlossTelescoping LaddersThread Milling TapsMat BagsRetractable LeashesJumpsSceneryControl PantiesGrab HooksCleats & ChocksFeeding SuppliesPod StandsAir PumpsRoofsBook RacksCorrection TapeCutlery SetsHand WrapsArchitecture KitsActivity CentersBusiness Card CasesCarbon CanistersArithmeticPlus Size PulloversMixing TraysRiding GlovesSissy BarsGravy BoatsHolding DevicesLeotardsRod & Reel CombosNeedlesSpringersBasic CratesBirdbath AccessoriesElectric ScootersFirewood RacksSuncatcher SuppliesPlate Serving CoversFloor Machine PadsSalad PlatesComputer VacuumsDiverter ValvesWrist RestsRing PacksPower WindowPress-In InsertsInstrument CablesLoupesDrumsticksBirdcage StandsWood Art BoardsWall PlaquesWind Speed GaugesCubbiesChandeliersAxes & HatchetsBirdbathsArtists' ManikinsArtificial BaitEarplugsCounter PensSheet PansBath ToysBilge PumpsIroning Board CoversSuspension ForksSpot LightsPlush Toy PillowsDash AccentsBreather FiltersTwineAntenna ToppersStraight RazorsLidsBite IndicatorsFire PitsThrow PillowsLaptop BackpacksMeasurement KitsGear SetsHook & Loop StripsHydraulicCloths & TowelettesStrandsShaftsGaragesHarnesses & LeashesDistance BallsBeach BallsJeep Hard TopsMedia PlayersBarometric PressureWater BalloonsFeathers & BoasProjection EffectsKVM SwitchesWater PurifiersNozzlesPlus Size TankinisJump RingsCable StaplesBlack Light BulbsExterior LightingOther (Football)Mop HandlesDVD RacksPendants OnlyBath TubsSolar ChargersDelay & ReverbCounted KitsSuit PantsHose TypeAngle BroomsGeometry SetsCandle SetsShopping Cart CoversAir IonizersLumbar PillowsWreath HangersWheel StudsChain AdjustersNight Vision ScopesBucketsOther (Earrings)Travel BowlsLuggage TagsStripsDream CatchersFuel Cleaning ToolsCompassesKitchen Linen SetsMonofilament LineWedding BandsSun SheltersKitesDash CoversBalletTea SetsEye GlossDash-Mounted HoldersWire ConnectorsWomen's Watch BandsSafety EarmuffsTubes & TunnelsInstant CamerasStuff SacksBed SkirtsDoor KnobsDrill Bit SetsHacksaw BladesInterior SetsParts WashersBusesBomber HatsHampersTrain TracksTraining GlovesTube CuttersFry Basket RacksSheet Music FoldersBakeware SetsMetalworking ChiselsChip & Dip SetsTackle BoxesOther (Fishing)Play TentsCoil PacksInterlocking TapePanel ScrewsPipe InsulationValancesPaddlesCabinet AccessoriesCleaning ToolsString BraceletsFlip-FlopsPoker SetsBall PitsSkinsMagnetic BasesHood VentsGrip TapeFluid EvacuatorsRocker SwitchesActivity CubesTeaching ClocksSpeaker BoxesCamera MountsLingerie BagsKaleidoscopesExterior ShowersPortable CD PlayersNeedle HoldersSerapes & PonchosAirbrush SetsVehicle HarnessesBracesSeat Belt PadsEffects FiltersIntercoolersDoor HangersPlus Size BlazersChineseNippers & SnipsFurniture PadsRadiator ShroudsSound & Noise MetersTip-Out TraysComfort MatsShot GlassesFrame GuardsToilet Flush ValvesComplete SetsRound Ring BindersGas Tank ProtectorsShade SailsIndex CardsConcealerCouplersRacks & StandsSport SandalsTail Bags3D Printer PlatformsSleeve AnchorsShiftersHeadlight CoversAir FiltersHandle PartsComputer ScrewsExhaust ToolsEngineers' HammersChristeningProject FoldersCocktail PicksNail-In HooksAnkle BracesHandbellsHammock StandsMid-PipesReinsBuffet TongsColored PencilsShade Sail HardwareWarning AlarmsCompressed AirRain ChainsParty FavorsMultifunctionPlus Size Sleep SetsTumblersBand Saw BladesPool LaddersCottonAnswering DevicesChocksBathroom FaucetsMicro Drill BitsLab LadlesU-BoltsAddress PlaquesBoard BagsSteak SetsIce MakersClarinetWhistlesComputer HeadsetsStaff BoardsStampers & ScrapersMicrophone CablesMelamineRacing ApparelNecklaces & PendantsGoalpostsBeadExternal Hard DrivesScrewGlass SheetsPoufsWindowComfort BikesMixersSki BagsCan LinersCamera BracketsDish Drying MatsBoard ShortsQuill PaintbrushesToiletsOther (Blades)Reading LightsEngine GuardsFilbert PaintbrushesCotton BallsPipe LocatorsSalts & SoaksEngine MountsToggle ClampsBridal SetsAmplifiersKey BoxesTactical Knee PadsFinsPricemarker LabelsIce TongsTeeth BoxesComponent SubwoofersStandardCollectible DollsPuzzle Play MatsSimulated CamerasClockRoll Bars & CagesDisc GuardsPropellersDoor HandlesLinesBrake AccessoriesTea Storage ChestsWashdown NozzlesElectronic IgnitionPrice Tags & HoldersPool Vacuum HeadsRotorsLock BoltsActive SkirtsFaucet Water FiltersFace JewelsChef JacketsNail CareEssential Oil BlendsMarker BoardsWipe HoldersTank BagsOver-the-KneeSatellite RadioCrash-RideContour CreamsDepilatoriesStretch WrapCarpetSnatchDouble LeashesGravelBean Bag Game SetsGear BagsFiguresScience Kits & ToysMetal DetectorsCameras & MonitorsHead RestsPlace CardsTravel WalletsPrecision BallsToe SeparatorsHaspsMultitoolsPatio Dining ChairsStrollersBait RigsPaint-By-Number KitsLab TraysFace BeltsBadge InsertsMosquito ProtectionPlaysetsSawsPin VisesFood StorageNail Polish RemoverSequential PuzzlesAirplanesRuffle TrimButcher PaperTrowelsPrinting & StampingCaposBar EndsPot WaxCord LocksChef's PansPlaymatsKnife SetsToners & AstringentsDuctingThermosesSinkers & WeightsCable LocksDress FormsMonitorsFoot MasksChain GuardsFirst Aid KitsToilet SeatsGarlic PeelersStore Sign HoldersCentral Vacuum BagsDevelopersCake Decorating KitsTops & CorsetsGrille InsertsThimblesCardboard CutoutsCloset ShelvesShock KitsParent Cup HoldersWindow TintsFloat TubesNon-Sterile GlovesSolventsPruning ShearsEmbossing FoldersFaucetsOther (Bike Locks)Suspension ToolsCablesDollhousesSuit HangersDry Erase SheetsSwivels & SnapsSeafood KnivesMagnetic TapeOther (Bags & Cases)Power & Ground CableVibration DampenersTires & WheelsPortable DVD PlayersCV BootsDiving LightsHosieryStep RailsCPU Cooling FansNetting SuppliesHarnessesBody Self-TannersProcedure TraysGame CollectionsDip PowderMount & Bracket SetsStationeryDiamond BladesDowel PinsWall PlantersValve Train ToolsPersonal RadiosFloral MossDessert ForksDetanglersPipingBlocksBead MazesNecksBreathalyzersGrip AidsEmergency RadiosBucket OrganizersAcrylic Nail KitsHair ColorMounting HardwareWind & BrassOil Filler CapsStrappingDisc SandersBicycle TrailersFloor PuzzlesSashimi KnivesBelly BandsTV AntennasDrippersPalette CupsMask DefoggersHose Repair KitsBoys'Sock & Stocking AidsFitness CirclesAlarms & Anti-TheftHobo BagsKeyedHeat Set InsertsFly Tying KitsOpen Fire CookwarePedal ExercisersVentsWaist TrimmersPottiesSudokuSet ScrewsBarbecue ForksButter DishesOther (Two-Pieces)Face OilCarrier OilsSnow BibsPeopleFuse & Perler BeadsMicroSD CardsGift Wrap StorageBonsai Training WireLeader RiggingGarden TwineEarring JacketsTubesOxford & DerbyToothpick HoldersCanister FiltersHuntingCombination BoardsShirt StudsPillow ProtectorsFittingsCar CradlesRain CoversStud FindersJig Saw BladesMagnetic Page AlbumsRegenerative BlowersCV Boot ToolsNonfictionToddler ShoesOil Supply LinesPedal PadsDrywall AnchorsHandsawsOutlet SwitchesToilet Seat CoversTapeManual Grinders3.7VPromise RingsRhinestonesUnder-Seat ConsolesStovetop Tea KettlesHair Perm RodsDecoysChamferReaction BallsCamping GrillsPainting SuppliesMaterial LiftsPianos & KeyboardsAwnings & SheltersSheet FastenersBias Tape MakersFlat FilesLug Nut CoversTire Repair KitsCuring LampsSmokersAshtraysFloor PumpsCereal ContainersBinding MachinesCrate CoversPSA DiscsPitchforksTool & Gadget SetsStamp BlocksEau de ParfumOther (Erotica)Mud GuardsCarry BagsBird BathsYo-yosButyl TapeTrachten ShirtsWall CrossesCorner RoundingKickballsPlus Size SweatpantsBike Travel CasesSnow PantsTangasIce ScrapersBlade FusesDoor Back OrganizersBus TubsTurn Signal LensesTrapsPlus Size Sleep TopsWiringFloor TraysPoweredArch SupportsSolar Power KitsToy Bags & NetsClassicsGlittersTacksNotecard SetsSymbol SignsChalkboardsWire RopeFeeder AccessoriesSetting SprayPouchesT-HingesCoin & Button CellDecking NailsCircular Saw BladesJet KitsRope CaulkLoppersGaming MiceCanister BagsHair PinsAccount BooksBody KitsTV Mount StandsFrame SlidersCotton SwabsCooking UtensilsWeathervanesLatch Hook KitsCapacitance MetersChamoisEyepiecesGlue GunsHandrailsDressing ToolsBolo TiesPlug FusesHornsFuel Tank CapsDryer SheetsOther (Card Games)Hub Centric RingsToothbrushesDrop-In AnchorsRace TracksArchival BoxesEar SyringesOther (Hoses)Hand & Wrist BracesToothpicksPlus Size DenimGrooming WipesFoam AmmunitionFlat FrontVanity Sink TopsWindow Hardware SetsDinner KnivesFantasyPersonal GroomersWall RepairHelmet HardwareAcorn NutsVinyl CarePreserved FlowersBlindsThumb PianosPlus Size JacketsDrinking JarsJewelry OrganizersDoor ClosersContemporaryTaperedRubber FlooringDoor LeversRacks & DisplaysBreechesMiniCoffee & Tea PotsPlanner CoversTowel-KetsKnife StorageAwningsSliding DoorsManifoldsHoesBrake FluidsAgility PolesServing BowlsBibsFrequency CountersBatting CagesSwingsChafing DishesKitchen Towel HooksPorous-Point PensWire StrippersTapping InsertsCrochet ThreadOpticsDouble-End BagsSafe AccessoriesPaper Roll CuttersFoam BoardsArmbandsChain & AccessoriesRouter FencesWheel Bearing ToolsLanyardsArborsAttractantsPitchersCup CarriersWaterproof JacketsSelfie SticksHideoutsOther (Kitchen)Push BroomsFishing ChairsOther (Wall Art)Light GuardsPlay TunnelsInflatable Ride-onsOil DrainsBursLicense Plate LightsHandheld BagsGrill ToppersBoardsManicure TablesBook StandsHandle NutsTenderizersPaw ProtectorsHand FansBeaded TrimBowlsOther (Stamps)Metal Casting MoldsBody WashesBumper CoversStarter KitsMandolin AccessoriesPipe FittingsBeer Mugs & SteinsCheese MakersHolePocket ChartsMetal Filled EpoxiesSoft-Shell CarriersWater ChangersHelmet BagsPatio Heater CoversVanity TraysMessage PadsMetal Bar GratingFood MillsHurdlesHand HonesTire CoversFrenchHeadlinersSpursMalletsSpokesStool CoversStorage CratesInsulatorsElectric Can OpenersEncaustic PaintingsReagent BottlesLaddersStrut RodsAdhesive BumpersSalad TongsLatticeBox WrenchesCaliper Kits & SetsConcentrator NozzlesVehicle RampsAftercare ProductsChinese MedicineRimsCandle ShadesMusic LyresCake ToppersConvertibleLighting ChainsBarbecue Tool SetsClaw HammersPool HosesDisplay BoothsShoesPayroll BooksSelector ValvesCheese TraysOverbed TablesLug RacksAnchors & BasesElectroscopesBirdcage LinersTraction PadsGlazesBurner RingsRCAHand MixersWood ScrewsOther (Fuel System)Oscillating ToolsTrash BagsArea Rug SetsStandard OutletsGeneratorsCPAP AccessoriesGate LatchesMilling InsertsTuning PegsControl UnitsPens & MarkersFishing HatsUniform Dress ShoesCitrus JuicersBoat ShadesTerrariumsSubwoofersMechanical TestersPainting ToolsVideo Wall MountsMemo & Scratch PadsDecoration KitsKeycapsFocus BagsWork WearRotary TrimmersMirror SetsRain SuitsNursing SuppliesCarton Sealing TapeStroller ConnectorsHive KitsTeam Practice VestsSweepersShelf DividersCamshaftsTattoo InksSugar SetsNeck BracesOther (Housekeeping)Semi-MountedPlus Size OvercoatsTack StorageShoe MountsStage SubwoofersWater BladesBackguardsCoupe Soup BowlsTeaspoonsKeyboard SkinsBall Joint ToolsHeadlampSmart RobotPole SetsFoilsGarage Door SealsPopcorn PoppersLED & LCD TVsStackersCriticismCartridge RazorsPiercing NeedlesKabuki BrushesSouffle CupsFixed-Blade KnivesCuticle PushersBivy SacksGrinding DiscsTrumpetPlus Size JumpsuitsAquarium StandsCartridges & RefillsT-NutsWheel Repair KitsKnife BlocksHair Drying TowelsWeighted Club SocksRetaining WashersScreen DoorsBike BellsHot Glue SticksPizza CuttersPlus Size BurqasGamesFog MachinesParachutesScrubsEssential Oil SetsDecorative MarblesSpringformPads & MatsHarpsScreen HousesNet PostsPegsHome Theater SystemsVideo Game ChairsVanity SuitesElectric KettlesWrapsWatering SuppliesScroll SawsID CasesHood ScoopsOutdoor ThermometersTiming Belt PulleysSolid Wood DeckingTail Light CoversDirectors ChairsSpark-free Tool SetsBicycle CarriersEyeglass ChainsOther (Hitches)Center CapsVanity BenchesReaching AidsSteel DrumsIndoor VolleyballsShin GuardsGrill ClothCommercial SteamersEntry TablesLogic ProductsQuick-Release SnapsArt BladesBand SawsUtility PumpsBakersPlastic LaceSkateboardsDress CoatsPom PomsRebuild KitsStands & BasesStamp Pads & RefillsMakeup PalettesPincushionsShower Bases & PansProgrammableSqueeze ToysFortune Telling ToysOffice CabinetsCotter PinsHobby Tool SetsSewing Project KitsOil FiltersCandle SconcesDrill Bit SharpenersKilnsMaintenance KitsFoundationsMuffin TraysCopper WireSlime ToysBake & Serve SetsBathroom SafetyMaze PuzzlesBasket MakingOne-Piece SuitsManual WeedersArt BlendersLighting ProductsRug PadsAnglesDownriggersSquirt GunsOrganizersFillet KnivesRight-Angle DrillsConstruction PaperSound ShieldsPond NettingSnow ShovelsCord ReelsRoller ShadesSpade Drill BitsStepstoolsHighchairsLinersCouchesBall WindersSupport StandsSoup-Cereal BowlsSteak KnivesBath Towel WarmersStolesWorkseatsFlashingHandlesetsProjectorsFood IndustryServosBindingsTurntable CartridgesFryer PotsOffice DesksPicksLiving Room SetsDock CleatsRain BarrelsCard PlayingBed MattressesBraidsSwim RingsHard-Sided CarriersCommercial SinksIce BucketsGrey CardsClocks & WatchesReservation BooksLinking KitsTortilla MakersShaved Ice MachinesWind SculpturesGrowing Light BulbsCookie JarsOther (Glass Care)Jig SawsSnow BlowersPlus Size AbayasBody PillowsCanopies & CoversStepping StonesHEPA Air PurifiersNesting TablesUtensil SetsIsland LightsRoof CapsDouble BoilersGrass CatchersProjection ScreensFreestandingKimonosTackle Storage TraysHose ReelsHot TubsLiteratureExfoliating GlovesTweezersBelt DriveWheel SpacersPanelingPasta ContainersBall ValvesIgnitionDoor PanelsClock MovementsLeg ExercisersGift Wrap CellophaneAllergiesPower CablesBack CoversCotton Pads & RoundsSteak WeightsDeodorizersCord EndsVentilationTap ExtractorsOil SprayersSport HeadbandsWindow OpenersWeaving LoomsHair AccessoriesHighway BarsHex KeysDrinking GamesFloor PansAngleCargo NetsCurtain PanelsLocksPhilosophyPooper ScoopersElectric ClippersThermostatsHorseshoesLighter PouchesSpoonsChargers & AdaptersCash TraysClocksWindow BoxesTraining MatsBobbinsCoolantPoker ChipsSweater SkirtsCuckoo ClocksBidet SeatsMail BagsBirdhousesWood Joiner NailsCornhole BoardsPicture FramesSide TablesGas CansWandsBaby Boys SweatersSmart SocketBiometricBeginner KitsReplacement Mop PadsBaby Girls SweatersFinish NailsPortable WashersElectronicsBread MachinesKnitting PatternsPottery WheelsPursesOpen-Ear HeadphonesUtility TablesLife Jackets & VestsDanceArmrest LidsTailgate LaddersLaundry SortersTraditional LaptopsHitch LocksLantern FlashlightsHydration BeltsMoney ClipsLinkagesTrainsKaraoke MachinesMonitor ArmsMooring BuoysBike HornsHammock Tree StrapsMemory BooksFiling CratesTeethersHand ExercisersBall-Knob HandlesOther (Hammers)Irrigation TubingCenter SupportsPillow ShamsTest Tube ClampsServer ShirtsDutch OvensAir IntakeBar Code ScannersCounterboresOutlet BoxesTonneau CoversUnderlaymentsRacquetsAnchorsOther (Flats)Floating CandlesSpinningBooster PacksHand PuppetsCoaxial CablesTool HolstersNeon Light KitsScientificBrush & Pen CleanersCD PlayersPleatedDifferential SensorsBoat CoversYard SignsDecorative RocksScratchboardsTable WarmersSheet GasketsCloth ShoesBaskets & LinersSkimming NetsNotionsAnkle WrapsSanding TapesEvent SheltersWood LathesNight CreamsBoxingMetallic PaperTriangular ScalesPlus Size RobesFinish CompoundPuttyGaming TopsRunningTransformersGame Bags & BeltsPearlsNail GlueSlot CarsInsect NettingTumbling MediaAddress BooksLeashesShoe Mount FlashesCD RacksIrrigatorsNovelty CandlesCrepe MakersO-RingsConnectorWrinkle PatchesMakeupData BindersCurling WandsMultiple StudArthritis GlovesFace Mill HoldersHoopsRefillsTerminals & EndsCornhole SetsBottle BrushesWheel BrushesStraight PinsTripod Mount RingsTaco HoldersBaseballsDisposable RazorsWire Rope ClipsCases & StorageStill LifeRelaysHall TreesBottle SetsDropping BottlesCoral OrnamentsDisconnectPatio MatsErasersPicnic TablesMagazine HoldersInksForward ControlsOutdoor Trash CansPassenger CarsInstructionalChaise LoungesInsert PuttersFire ExtinguishersNursing BrasComplete SeatsKraft PaperShakersPocketAxlesHumidity DomesSun ProtectionOrnament StorageGarlic KeepersCling StampsGrips & Grip TapeFootball StorageSound TherapyLight NovelsRC LinkagesWeighted BlanketsLantern AccessoriesRacing SuitsSequinsSoccerBrake CalipersOil TemperatureCornetGermanFM TransmittersFace MasksTrash PickersBag SealersTape ApplicatorsJammersDetailing ToolsHem TapePlus Size VestRubbersFootstoolsOne-Piece PajamasPailsSpikesBoat HooksShelf ClipsRice PaperLob WedgesSpare Tire CarriersWater HosesBathtub FaucetsBaby BoysStorytelling ToysHikingSpanishLamp FinialsLuminariasTablespoonsShort Stem FunnelsOther (Table Tennis)Furniture PaintMassage BallsBubble WrapFight GlovesDance SkirtsMount AdaptersBingo ChipsPaper PunchesG-Strings & ThongsCharger PlatesPasta Molds & StampsRepellent MatsFlatware SetLazy SusansDuffelsHard Shell CasesHitch MountsTransmissionsPolyhedral DiceSmart Ceiling FanRailingsLocating PinsBearingsSound BarsBocce SetsRazorsPads & EnhancersGourmetBatter DispensersApplication ToolsTrim RingsBoomVending MachinesFlute & PiccoloInterior LightFloor FansFerrule FittingsHandheld SteamersMulch KitsOcean DrumsFlap DiscsTreadmillsCat DoorsPassport WalletsStep MachinesRibbon StorageTwist BoardsPizza StonesIndoor Kayak StorageHome Digital PianosAdditivesNon-Woven BitsCut CardsMetronomesScrapbookingStrength TrainersDrumsHelmet LinersRainFoam TapeSeating MechanicalsFly Tying EquipmentPush & Pull CartsInjectorsUrinal Flush ValvesNeedle CasesOxfordFuton FramesFigurine OrnamentsOther (Furniture)Flower Girl BasketsLaundry LinersTreated Wood DeckingFruit KnivesMobility ScootersWood Carving ToolsBlush BrushesSanding BlocksFish Oil SupplementsWall Cut-OutsMemoryEyewear RetainersSalt ShakersCatnipFlexbandsPuzzlesBinding ScrewsPunchless BindersLetter OpenersBody ButtersPop Fidget ToysBattingMannequinsFuse BlocksSingleMoleskinPuttersWiggle EyesRingLetters & NumbersCarrying CasesCooked Meat TraysQuilling StripsTaper CandlesCream Soup BowlsAxesSpeaker RepairCake PansCandle LampsBingo DaubersStall SuppliesComponent SpeakersStone WarmersSidingFoot & Nail CareCastlesLeg MachinesMechanicalFermentersLatch Hook SuppliesCompression GaugesParts & HardwareJig Saw AccessoriesCraft SticksReusable FiltersEarphonesGirl's Denim TopsTow BarsAudio InterfacesEyelash CurlersSpinning TopsTravel PottiesFork SealsOther (Dresses)Hammock CanopiesShore Power AdaptersJump RopesLight CoversClock KeysHelmet ShieldsCuticle ScissorsKitchen FaucetsInstrumentDrawersShowers & BathtubsCanning & PreservingWebcamsCooling FansEducationJoint SealantsCanesHold Down ClampsProbioticsMarine EngineeringFood DispensersPack EquipmentCounselingSnacksArtPlanter UrnsLotion & Oil WarmersPaddle FansMobile File CabinetsFelt BobsOther (Tiles)Ball MountsInformation TheoryDressing Aid SticksResearchCash BagsThermometersMerchandising RacksReceiversSoufflé DishesWelding HelmetsOther (Favors)Sponges & MittsAppetizersCamcordersBully SticksManual Pole SawsMixed-MediaLitter BoxesSandboxesChampagne GlassesGraph & Data PadsShreddersUndergarment SewingTag Attacher GunsCash RegistersUpright BagsPlant LabelsBaby BathRollersFireplace FansAll-in-OnesPull Chain OrnamentsPedestal TablesRecliner SlipcoversHabitatsHeaters & FurnacesAida ClothKids' Road BicyclesStick HorsesStorage Drawer CartsFire TablesPads InsertsSwagsShoe Care KitsDigital ThermometersFoot BathConesPush Ride-OnsHeat Press MachinesMilling MachinesTire ChucksSmart Bedside TableTable TopsBass BlockersAC AdaptersBistro TablesCommercial GriddlesElectric ThrowsTinted MoisturizersBedroom SetsGas Cap VentsRefractorsNatural Gas GrillsConcrete MixersComplete KitsArt PastesStorage LockersCoupe Cereal BowlsPlus Size One-PiecesStamps & Print KitsReplacement SpeakersCovering PlasticOboeSink & Burner CombosProtective GearRotatingCymbal StackersDrop Slot SafesFile Folder FramesTrimmer BladesFrench PressesOther (Hinges)Diorama KitsLug NutsSauna SuitsGrill BasketsGarden SoilFish BowlsCorrugated BoxesShower DoorsFlagWedding AlbumsEgg SlicersOther (Latches)Other (Model Kits)Flame EffectsToy SwordsShowerhead FiltersStraight EdgesSewer HosesTracing PaperFurSugar ShakersAccessory PowerEqualizersTweetersBike BasketsCups & GlassesOther (Doll Making)Head SupportsJapanese PlanesSachetsHorizontal BlindsFragrant Room SpraysOther (Aluminum)SpeakerFork AdjustersIce Cream MachinesTinted Lip GelVegetable CleaversMatcha WhisksPower AmplifiersSpringDocument FramesWool Ball TrimmerSpraysSkee-BallWoks & Stir-Fry PansBlotting PaperDoorbellsRace SetsTest StripsBunion PadsSundial ClocksHighlighter TapeSafety KitsBreath FreshenersFoot SupportsSolid RivetsRearsetsSharpsBikesDesignsBarbecue TurnersCollar StaysAAANursing CoversOTG AdaptersTick Remover ToolsPool RaftsOveralls & CoverallsMultifunction ToolsReusable RespiratorsStoplightGrilling CharcoalInk StoneFinger SleevesTube Adapter NutsHolisticSpine SupportersBleachingToilet Spare PartsDigital PensAdhesive DotsPhono PreampsDisposable FiltersDrums & PercussionTrackersHand MasksWaxing KitsLiquid DetergentPhoto & Video KitsEgg SeparatorsGirls'LuminometersBinsGazing BallsLaser RangefindersRegulatorsKickboardsRice BowlsMetallophonesCarTransit SacksRidge FillerChain BlocksGift BasketsEyebrow TrimmersCream & Sugar SetsFloral PicksECUsBarbed FittingsStrap CoversOil Filter PliersOther (Engine Parts)Paddleboard BagsQuilt StandsTapered HandlesEdge ClampsOrgan AccessoriesKeepsake FramesTinted Lip OilTactical PouchesSkortsInterdental BrushesPocketsSafety RampsPomsLamps & ShadesArt GluesJack StandsAir Tool Hose ReelsPneumatic WheelsJewelry PatternsBowlingFelt Applique KitsButter KnivesLow CholesterolLamp SetsBiographicalBordersExtension LaddersLadder ShelvesRuler RacksSponge MopsDecking ScrewsPackaging TapeGarden BridgesProjection ClocksAnimalsPlungersY FittingsSpeed BagsBass Drum PedalsCO2 PumpsCoilsSoil Test KitsLighting AccessoriesHand-woven ShoesLag ScrewsID WristbandsBarbellsIgnition CoilsCharger SetsStar DriveBidet AttachmentsOther (Cheerleading)Floor BoardsWeapon CasesSkate AccessoriesLuggage Handle WrapsCar & Truck RacksFuse AssortmentsClamp-OnClay PressesBundles & ClosureCommercial MixersCourtesy LampHook StrapsWrist WrapsOther (Netball)Push-Pull KnobsBathtub DrainsMounting EquipmentFuton MattressesStep StoolsSporransSatellite SpeakersKeffiyeh & ShemaghCharcoalsCup LidsClothes DryerGolfSpeed Bag StandsCar Stereo ReceiversCruise ControlBed RisersCargo RacksPowered MixersVehicle MountsEar CareHome Fragrance LampsSalon & Spa TablesNeck BrushsRim Brake SetsWindshield LowersCargoWire Rope CuttersDance TightsElastic CordsRoasting PansDisposable UnderwearSlipcover SetsOil RestrictorsControl ArmsCycling JerseysWoodcutsWatercraft KitsDiodesBindings & TrimVent ControlScrapbooking ToolsFixturing ClampsCrossover PartsMeasuring PipettesSignboardsHandlesRecreationalNibblersHardboardStrawsTrail RunningDial IndicatorsPacksRound Belt PulleysPartsDrain StoppersEtching AccessoriesSlingsGasketsClamp MetersAlnico MagnetsEnergy ControllersFork OilSuggestion BoxesOther (Valves)Spring LoadedDough BlendersPipe TapsRectangularChain SlidersMixed Media PaperThermal PadsRattlesBroom HandlesKite AccessoriesNut Driver SetsGarmentsCordageDaubersHard HatsElectrical BoxesEnamel PaintingsSide DishesSeafood ToolsKneepadsBikini TrimmersMusical HornsWalkersOther (Disposables)Other (Running)BoomerangsBar ClampsLitter ScoopsTactile SwitchesFabric AdhesivesCooling SystemsWeather StationsPower AdaptersBoostWire Fencing StaplesMulti-StylersHandheld FiltersSeparatorsSpotting Drill BitsNoisemakersClock LightsVellumUpholstery CarePocket ProtectorsBasketball JerseysEmbroidery StorageSplash GuardsTail LightsPlace Card HoldersCrossedTray RacksTurbochargersKneeling ChairsPaint Roller FramesPaint AdditivesPie PansTubingMassageModeling MaterialsScrewsPlayardsTrainer AccessoriesFelt SticksDoiliesBackstopsOther (End Mills)DethatchersNut InsertsPaint Roller SleevesSoil MetersShift ShaftsOther (Sewing Tools)Dock GuardsCables & ChainsPaper CraftWool RovingSunroofBall JointsFilmWind-up ToysAquarium NetsTime CardsAccessory LightsCountersink BitsFiber Optic LightsBlind RivetsSanding PadsBathtub AppliquesCast & Wound CoversAyurvedic Skin CareOther (Wheels)Foot SwitchesCutter SpacersMop PaintbrushesRear WheelsCat 7 CablesWeapon StandsMicroscopesTelephone StandsSmart SwitchHall Effect PickupsPen ErasersEgg BasketsHeadsetsHairbangsElectric KnivesPoster BoardsBurqasClogs & MulesBlank CanvasTailgate LocksLighted Exit SignsCold FramesOther (Printers)Pool Ground ClothSprayLaminatorsDD CreamsOther (Laps & Hones)Panel Flange ToolsBacksFacial SteamersCuticle NippersSide CombsLip maskWine PourersStraight FittingsMegaphonesCarpentry SquaresDimmersCD Storage CasesTracing ToolsArm WarmersScrewdownsMasonry HammersTire PensBusiness EnvelopesOther (Vehicles)Storage & OrganizersSiding NailsSalon & Spa ChairsHiking ShoesEye CareSide Milling CuttersLeatherDuffel BagsPalletsCommercial BroilersShadow Boxes
TEMU TXDSONG Premium PVC Vinyl Wrap Auto Fahrzeug ...
kostenloser Versand, schnellerer Kundendienst
43.99
14.8566% OFF
TEMU 체슈종 레드 PET 카본 파이버 비닐 랩 - 19.69x59.06인치, 방수 및 ...
Temu에 있는 저렴한 상품, 신규 사용자 첫 주문 무료 배송
40,591.00
16,937.0058% OFF
TEMU 1롤 30*200cm/11.81*78.74인치 자동차 필름 자동차 후방 거울 자전...
Temu에 있는 저렴한 상품, 신규 사용자 첫 주문 무료 배송
19,019.00
8,414.0056% OFF
TEMU For Headlight Tint Protection Film - Tpu Smok...
Faster shipping. Better service
61.86
28.7753% OFF
TEMU Autokarosserie Chrom Beschichtung Modifikatio...
kostenloser Versand, schnellerer Kundendienst
23.99
12.3049% OFF
TEMU PET Gold Und Geschmiedeter Ethylen Verpackung...
kostenloser Versand, schnellerer Kundendienst
€9.07
€4.8247% OFF
TEMU Diamond Auto-Folienfolie - PVC- Außenverkleid...
kostenloser Versand, schnellerer Kundendienst
14.49
8.4941% OFF
TEMU Matte Cherry Red Car Wrap Film, 50x150cm - Du...
Faster shipping. Better service
AU$99.56
AU$76.6223% OFF
TEMU & Vinyl Wrap Film - High Quality Durable Deco...
Faster shipping. Better service
AU$100.16
AU$78.0022% OFF
TEMU A Large-sized Pet Carbon Fiber Car Wrap Measu...
Faster shipping. Better service
60.22
49.4518% OFF
TEMU 대형 100*152CM PET 전기 도금 텍스처 슈퍼 매트 독성 그린 차량 랩 필...
Temu에 있는 저렴한 상품, 신규 사용자 첫 주문 무료 배송
55,021.00
51,787.006% OFF
TEMU Envoltura para Coche Cheshjong - Vinilo Elect...
Precio bajo con envío gratis para usuario nuevo.
846.49
121.0686% OFF
TEMU PET用の色が変わる、車体用の2Dホログラフィックカー、携帯電話の背面用カー、高光沢で色が...
Temuアプリをダウンロードして、ショッピングを楽しもうTemuならではの手頃な価格でアイテムが手に入る送料無料を今すぐ楽しもう今すぐショッピング品質と良い価値の商品がセール中 Temuで驚きのアイテムを発見しよう
7,458.00
1,673.0078% OFF
TEMU Tngletn 3d Fiber Vinyl Wrap - High-definition...
Faster shipping. Better service
kr527.10
kr137.5174% OFF
TEMU Sparkling Metallic Blue Vinyl Wrap Film – Pvc...
Faster shipping. Better service
25,736.00
6,764.0074% OFF
TEMU Diy Car & Motorcycle Decal - Pvc For Exterior...
Faster shipping. Better service
€35.49
€9.3674% OFF
TEMU 24 Pcs Fiber -scratches Car Cup Film Universa...
Faster shipping. Better service
AU$52.39
AU$14.5172% OFF
TEMU Karlor Glossy Car Sticker Car Wrapping Film V...
Faster shipping. Better service
€25.90
€7.5271% OFF
TEMU Pet Liner Purple Carbon Vinyl Film With Bubbl...
Faster shipping. Better service
€31.49
€9.9169% OFF
TEMU Cheshjong Regenbogen Autoverklebung - Kupfer-...
kostenloser Versand, schnellerer Kundendienst
€29.99
€9.5368% OFF
TEMU Car Motorcycle Color Changing Film, Frosted *...
Faster shipping. Better service
143.21
47.7767% OFF
Subscribe to Temu coupon newsletter
Get notified of offers and coupon codes from Temu before they expire!